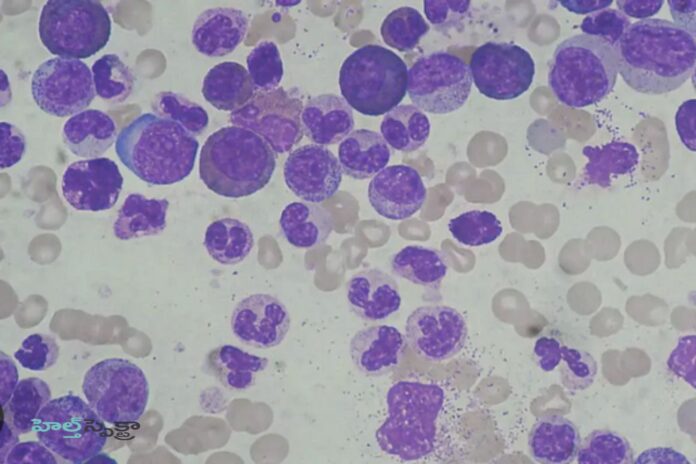
Leukocytosis_ causes, Symptoms & Treatment

బ్లడ్ రిపోర్ట్ (రక్త నివేదిక)లో తెల్ల రక్త కణాలు గణన పెరిగినట్లు చూపిస్తే, అది ఇన్ఫెక్షన్, వాపు లేదా రోగనిరోధక వ్యవస్థ రుగ్మతకు సంకేతం కావచ్చు. భారతదేశంలో ప్రతి సంవత్సరం లక్షలాది మంది ప్రజలు ఈ సమస్యను ఎదుర్కొంటారు, కానీ చాలా మంది దీనిని తేలికగా తీసుకుంటారు. ఆరోగ్య నివేదికల ప్రకారం, భారతీయ పెద్దలలో సుమారు 12–15 శాతం మందికి అసాధారణ తెల్ల రక్త కణాలు గణన ఉంటుంది, అయితే అమెరికా మరియు యూరప్లో, ఈ సంఖ్య దాదాపు 10 శాతం. రక్త కణాలు పెరగడం వల్ల రక్తం పెరుగుతుంది. ఇది మంచి పరిణామమే. అయితే రక్త కణాలలోని ఎర్ర రక్త కణాలు పెరిగితే అది మంచిది.
కానీ తెల్ల రక్త కణాలు పెరిగితే మంచిదేనా.? అసలు తెల్ల రక్త కణాలు పెరిగినప్పుడు ఏమి జరుగుతుంది? అన్న ఆసక్తి కూడా అప్పడప్పుడు మనలో కలుగుతుంది. అదీ మన తాజా రక్త నివేదికలో ఇవి పెరిగి ఉన్నాయని తెలిసినప్పుడు ఈ ప్రశ్నలు ఉత్పన్నం అవుతాయి. దీన్ని అర్థం చేసుకోవడం చాలా ముఖ్యం, ఎందుకంటే ఇది మీ శరీర రోగనిరోధక వ్యవస్థ యొక్క స్థితి మరియు ఆరోగ్యం గురించి ముఖ్యమైన సమాచారాన్ని అందిస్తుంది. ఇది ఇన్ఫెక్షన్, వాపు, అలెర్జీలు లేదా కొన్నిసార్లు తీవ్రమైన అనారోగ్యాల వల్ల కూడా సంభవించవచ్చు. మీరు తరచుగా అలసట, జ్వరం లేదా బలహీనతను అనుభవిస్తుంటే మరియు మీ నివేదికలో తెల్ల రక్త కణాలు గణన పెరిగినట్లు చూపిస్తే, అది అంతర్లీన ఇన్ఫెక్షన్ లేదా మీ శరీరంలో అసాధారణతకు సంకేతం కావచ్చు.
తెల్ల రక్తకణాలు పెరిగితే? What happens in Leukocytosis?

రక్తంలో తెల్ల రక్త కణాలులు పెరిగినప్పుడు ఏమి జరుగుతుందో అర్థం చేసుకునే ముందు, తెల్ల రక్త కణాలులు ఏమిటో మరియు మన శరీరంలో వాటి పనితీరును అర్థం చేసుకునే ప్రయత్నం చేదాం.
తెల్ల రక్త కణాలు అంటే ఏమిటి? What are white blood cells?

తెల్ల రక్త కణాలుల పూర్తి రూపం తెల్ల రక్త కణాలు. అవి మన రక్తంలో చాలా ముఖ్యమైన భాగం, ఎందుకంటే వాటి ప్రధాన విధి ఇన్ఫెక్షన్లు, బ్యాక్టీరియా మరియు వైరస్ల వంటి హానికరమైన పదార్థాల నుండి మన శరీరాన్ని రక్షించడం. అందుకే తెల్ల రక్త కణాలులను శరీరం యొక్క “రక్షణ వ్యవస్థ” అని పిలుస్తారు – వ్యాధి నుండి మనల్ని రక్షించడం. తెల్ల రక్త కణాలులు మన ఎముకల లోపల (ఎముక మజ్జ) మృదువైన, స్పాంజి కణజాలంలో ఉత్పత్తి అవుతాయి. శరీరంలో ఇన్ఫెక్షన్ సంభవించినప్పుడల్లా, ఈ కణాలు వెంటనే సక్రియం అవుతాయి మరియు దానితో పోరాడటం ప్రారంభిస్తాయి. అందువల్ల, మనకు జ్వరం, జలుబు లేదా మరేదైనా రకమైన ఇన్ఫెక్షన్ వచ్చినప్పుడు, తెల్ల రక్త కణాలు కౌంట్ పెరుగుతుంది. శరీరం అంతర్గతంగా వ్యాధితో పోరాడుతోందని ఇది సంకేతం.
ఐదు ప్రధాన రకాల తెల్ల రక్త కణాలులు ఉన్నాయి. అవి న్యూట్రోఫిల్స్, లింఫోసైట్లు, మోనోసైట్లు, ఇసినోఫిల్స్ మరియు బాసోఫిల్స్. ప్రతి ఒక్కటి వైరస్లు మరియు బ్యాక్టీరియాతో పోరాడుటుంది, వాపును నియంత్రించడం లేదా దీర్ఘకాలిక ఇన్ఫెక్షన్లను తొలగించడం వంటి ప్రత్యేకమైన పనితీరును కలిగి ఉంటుంది. శరీరంలో తెల్లరక్త కణాల సంఖ్య చాలా ఎక్కువగా లేదా చాలా తక్కువగా ఉంటే, అది అంతర్గత సమస్య లేదా బలహీనమైన రోగనిరోధక శక్తిని సూచిస్తుంది. అందువల్ల, క్రమం తప్పకుండా తనిఖీలు చేయడం మరియు సమతుల్య తెల్లరక్త కణాల స్థాయిని నిర్వహించడం మన ఆరోగ్యానికి చాలా కీలకం.
తెల్ల రక్తకణాలు పెరిగితే ఏమవుతుంది? What happens if WBC increase?

రోగనిరోధక వ్యవస్థపై ఒత్తిడి Stress on the immune system: అధిక తెల్లరక్త కణాలు శరీర రక్షణ వ్యవస్థను నిరంతరం చురుకుగా ఉంచుతాయి, రోగనిరోధక వ్యవస్థపై అనవసరమైన ఒత్తిడిని కలిగిస్తాయి మరియు దీర్ఘకాలికంగా దానిని సమతుల్యం చేయడం కష్టతరం చేస్తాయి.
యాంటీఆక్సిడెంట్ సమతుల్యత అంతరాయం Disruption of antioxidant balance: పెరిగిన తెల్లరక్త కణాలు శరీరంలో ఆక్సీకరణ ఒత్తిడిని పెంచుతాయి, కణాలు దెబ్బతినే ప్రమాదాన్ని పెంచుతాయి మరియు శరీర శక్తిని తగ్గిస్తాయి.
అంతర్గత అవయవాలపై ప్రభావం Impact on internal organs: పెరిగిన తెల్లరక్త కణాల హాని కాలేయం, మూత్రపిండాలు మరియు గుండె వంటి అవయవాలపై అదనపు ఒత్తిడిని కలిగిస్తుంది, వాటి పనితీరును ప్రభావితం చేస్తుంది.
మానసిక అలసట మరియు ఒత్తిడి Mental fatigue and stress: పెరిగిన తెల్లరక్త కణాల వల్ల మెదడు ప్రభావితమవుతుంది. మరియు నాడీ వ్యవస్థ. పెరిగిన తెల్ల రక్త కణాలు గణనలు మానసిక అలసట, చిరాకు మరియు దృష్టి కేంద్రీకరించడంలో ఇబ్బందిని కలిగిస్తాయి, కాబట్టి వాటిని విస్మరించకూడదు.
శరీరంలో మైక్రోస్కోపిక్ వాపు Microscopic inflammation in the body: పెరిగిన తెల్ల రక్త కణాలు గణనలు శరీరంలో సూక్ష్మ వాపును పెంచుతాయి, ఇది చాలా కాలం పాటు విస్మరించబడితే ఇతర ఆరోగ్య సమస్యలకు దారితీస్తుంది.
పెరిగిన తెల్ల రక్త కణాలు గణనలు ఎల్లప్పుడూ తీవ్రమైన అనారోగ్యానికి సంకేతం కాదు, కానీ అవి శరీరంలో ఇన్ఫెక్షన్ లేదా అసాధారణతకు సంకేతం కావచ్చు. మీ తెల్ల రక్త కణాలు గణన సాధారణం కంటే ఎక్కువగా ఉంటే, భయపడటానికి బదులుగా వైద్యుడిని సంప్రదించడం ఉత్తమం. సరైన పరీక్ష, సమతుల్య ఆహారం మరియు తగిన చికిత్సతో, తెల్ల రక్త కణాలు గణనలను సాధారణీకరించవచ్చు మరియు మీ ఆరోగ్యం మెరుగుపడుతుంది.
తెల్ల రక్త కణాల సాధారణ పరిధి? Normal range for WBC?

ఆరోగ్యకరమైన వ్యక్తికి తెల్ల రక్త కణాలు గణనలకు నిర్దిష్ట పరిధి ఉంటుంది, దీనిని వైద్యులు “సాధారణ పరిధి” అని పిలుస్తారు. వయస్సు మరియు ప్రయోగశాల ఫలితాలను బట్టి ఈ పరిధి కొద్దిగా మారవచ్చు.
వయస్సు సమూహం: రక్తంలో తెల్ల రక్త కణాలుల సాధారణ స్థాయి (మైక్రోలీటర్కు)
- పెద్దలు: 4,000 నుండి 11,000 కణాలు/µL
- పిల్లలు: 5,000 నుండి 13,000 కణాలు/µL
- నవజాత శిశువులు: 9,000 నుండి 30,000 కణాలు/µL
మీ తెల్ల రక్త కణాలు గణన 11,000 కంటే ఎక్కువగా ఉంటే, దానిని ల్యూకోసైటోసిస్ అంటారు, అంటే అధిక తెల్ల రక్త కణాలు గణనలు. ఇది 4,000 కంటే తక్కువగా ఉంటే, దానిని ల్యూకోపెనియా అంటారు, అంటే తక్కువ తెల్ల రక్త కణాలు గణనలు.
అధిక తెల్ల రక్తకణాలకు కారణాలు Causes of leukocytosis

శరీరంలో ఇన్ఫెక్షన్, వాపు లేదా బాహ్య దాడి సంభవించినప్పుడు, మీ రోగనిరోధక వ్యవస్థ దానితో పోరాడటానికి ఎక్కువ తెల్ల రక్త కణాలను (తెల్ల రక్త కణాలులు) ఉత్పత్తి చేస్తుంది. అయితే, ఈ స్థాయి ఎక్కువ కాలం సాధారణం కంటే ఎక్కువగా ఉన్నప్పుడు, అది తీవ్రమైన ఆరోగ్య సమస్యకు సంకేతం కావచ్చు. ప్రధాన కారణాలు ఇలా:
ఇన్ఫెక్షన్ Infection: బాక్టీరియల్, వైరల్ లేదా ఫంగల్ ఇన్ఫెక్షన్ సమయంలో, శరీర రోగనిరోధక వ్యవస్థ టైఫాయిడ్, న్యుమోనియా, టాన్సిలిటిస్ లేదా మూత్ర నాళాల ఇన్ఫెక్షన్ వంటి ఇన్ఫెక్షన్తో పోరాడటానికి ఎక్కువ తెల్ల రక్త కణాలు లను ఉత్పత్తి చేస్తుంది.
ఇన్ఫెక్షన్ వ్యాధులు Infectious diseases: రుమటాయిడ్ ఆర్థరైటిస్, ఇన్ఫ్లమేటరీ ప్రేగు వ్యాధి లేదా ఏదైనా దీర్ఘకాలిక వాపు సమయంలో, శరీర కణజాలాలు వాపును నియంత్రించడానికి ఎక్కువ తెల్ల రక్త కణాలు లను ఉత్పత్తి చేస్తాయి.
ఒత్తిడి మరియు శారీరక అలసట Stress and physical fatigue: దీర్ఘకాలిక మానసిక ఒత్తిడి, కఠినమైన శారీరక శ్రమ లేదా శస్త్రచికిత్స శరీరంలో తెల్ల రక్త కణాలు స్థాయిలను తాత్కాలికంగా పెంచుతుంది.
ధూమపానం మరియు అనారోగ్యకరమైన జీవనశైలి Smoking and Unhealthy Lifestyle: ధూమపానం, మద్యం సేవించడం, నిద్ర లేకపోవడం మరియు ఫాస్ట్ ఫుడ్ వంటి అలవాట్లు శరీరంలో విషాన్ని పెంచడం ద్వారా తెల్ల రక్త కణాలు అసమతుల్యతకు కారణమవుతాయి.
మందుల ప్రభావాలు Medicine Effects: కార్టికోస్టెరాయిడ్స్, లిథియం లేదా కొన్ని యాంటీబయాటిక్స్ తాత్కాలికంగా తెల్ల రక్త కణాలు గణనలను పెంచుతాయి.
అలర్జీలు, ఆటో ఇమ్యూన్ వ్యాధులు Allergies and Autoimmune Diseases: ఉబ్బసం, అలెర్జీలు లేదా లూపస్ వంటి వ్యాధులలో, శరీర రోగనిరోధక వ్యవస్థ సాధారణ పదార్థాలను “హానికరమైనవి”గా తప్పుగా భావించి అధిక తెల్ల రక్త కణాలులను ఉత్పత్తి చేస్తుంది.
రక్తం, ఎముక మజ్జ రుగ్మతలు Blood and Bone Marrow Disorders: లుకేమియా (రక్త క్యాన్సర్) లేదా ఎముక మజ్జ రుగ్మతలలో, అసాధారణ తెల్ల రక్త కణాలు కణాలు వేగంగా గుణించి, చాలా అధిక స్థాయికి దారితీస్తాయి.
అధిక తెల్ల రక్తకణాల లక్షణాలు? Symptoms of Leukocytosis

ఎలివేటెడ్ తెల్ల రక్త కణాలు గణనలు ఉంటే మీ శరీరం ఇన్ఫెక్షన్ లేదా రోగనిరోధక ప్రతిస్పందనతో పోరాడుతోంది. ఇది అర్థం చేసుకోవడం ముఖ్యం ఎందుకంటే ఇది మీ శరీరంలో అనేక సంకేతాలు మరియు మార్పులకు కారణమవుతుంది.
మీరు అనుభవించే అత్యంత సాధారణ లక్షణాలు:
- జ్వరం మరియు బలహీనత Fever and weakness: మీ శరీరం ఇన్ఫెక్షన్తో పోరాడుతున్నప్పుడు మీకు అలసట మరియు జ్వరం అనిపించవచ్చు.
- తలనొప్పి మరియు బరువు Headache and weight: అధిక తెల్ల రక్త కణాలు గణనలు తేలికపాటి తలనొప్పి లేదా భారమైన అనుభూతిని కలిగిస్తాయి.
- వాపు మరియు ఎరుపు Swelling and redness: కీళ్ళు లేదా చర్మంపై వాపు లేదా ఎరుపు కనిపించవచ్చు. ఇది మీ శరీర రక్షణలో భాగం.
- ఆకలి మరియు బరువు మార్పులు Appetite and weight changes: తరచుగా ఆకలి లేకపోవడం లేదా బరువు తగ్గడం మీ శరీరం నిరంతరం ఇబ్బంది పడుతున్నట్లు సంకేతాలు కావచ్చు.
- పునరావృత ఇన్ఫెక్షన్లు Recurrent infections: తరచుగా జలుబు, దగ్గు లేదా మూత్ర ఇన్ఫెక్షన్లు మీ రోగనిరోధక వ్యవస్థలో అసమతుల్యతను సూచిస్తాయి.
- చర్మం మరియు గోరు సమస్యలు Skin and nail problems: మీ గోళ్ల దగ్గర మచ్చలు, పుండ్లు లేదా వాపు కూడా కనిపించవచ్చు.
- మానసిక ప్రభావాలు Psychological effects: అలసట, చిరాకు మరియు దృష్టి కేంద్రీకరించడంలో ఇబ్బంది కూడా సాధారణం.
మీరు ఈ లక్షణాలను ఎదుర్కొంటుంటే, రక్త పరీక్ష చేయించుకుని వెంటనే వైద్యుడిని సంప్రదించండి. ఇది మీ తెల్ల రక్త కణాలు గణనలను అర్థం చేసుకోవడంలో మీకు సహాయపడటమే కాకుండా ఏవైనా అంతర్లీన ఇన్ఫెక్షన్లు లేదా ఆరోగ్య సమస్యలను ముందుగానే గుర్తించడంలో కూడా సహాయపడుతుంది.
అధిక తెల్ల రక్త కణాలకు చికిత్స? Treatment for Leukocytosis

కొన్నిసార్లు, అధిక తెల్లరక్త కణాలు శరీరంలో చిన్న ఇన్ఫెక్షన్ లేదా వాపుకు సంకేతం. ఇది ఎల్లప్పుడూ ఆందోళన కలిగించాల్సిన విషయం కాదు, కానీ దీనిని విస్మరించకూడదు. అధిక తెల్లరక్త కణాలు గుర్తించబడితే, వైద్యుడిని సంప్రదించి సరైన పరీక్షలు చేయించుకోవడం ముఖ్యం. సరైన చికిత్స, పోషకాహార ఆహారం మరియు కొన్ని జీవనశైలి మార్పులు తెల్లరక్త కణాలను సాధారణ స్థాయికి తీసుకువస్తాయి.
ఎప్పుడు వైద్యుడిని చూడాలి: When should you consult a Doctor?

మీరు పునరావృతమయ్యే జ్వరం, అలసట లేదా బలహీనతను అనుభవిస్తే లేదా మీ రక్త పరీక్షలో ఏవైనా అసాధారణతలు గమనించినట్లయితే, ఆలస్యం చేయవద్దు—వెంటనే వైద్యుడిని సంప్రదించండి. ఇది కొనసాగుతున్న ఇన్ఫెక్షన్ లేదా బలహీనమైన రోగనిరోధక వ్యవస్థకు సంకేతం కావచ్చు.
అవసరమైన పరీక్షలు Required tests:
వైద్యులు సాధారణంగా CBC పరీక్ష లేదా రక్త స్మియర్ పరీక్షను సిఫార్సు చేస్తారు, ఇది ఖచ్చితమైన తెల్లరక్త కణాల సంఖ్య మరియు రకాన్ని నిర్ణయిస్తుంది. ఇది వ్యాధికి మూల కారణాన్ని అర్థం చేసుకోవడానికి సహాయపడుతుంది.
చికిత్స మరియు సంరక్షణ Treatment and care:
చికిత్స సంక్రమణకు కారణాన్ని బట్టి ఉంటుంది. అవసరమైతే మీ వైద్యుడు యాంటీబయాటిక్స్ లేదా యాంటీవైరల్ మందులను సూచించవచ్చు. తగినంత విశ్రాంతి, పోషకమైన ఆహారం మరియు తగినంత నీరు తీసుకోవడం కూడా అవసరం—ఇవన్నీ శరీర రోగనిరోధక వ్యవస్థను బలపరుస్తాయి.
ఏమి తినాలి, ఏమి తినకూడదు? What to eat, what not to eat?
శరీరంలో తెల్ల రక్త కణాలు ఎక్కువగా ఉన్నప్పుడు సరైన ఆహారం తీసుకోవడం చాలా ముఖ్యం. సమతుల్య మరియు పోషకమైన ఆహారం తీసుకోవడం ద్వారా, మీరు మీ తెల్ల రక్త కణాలు కౌంట్ను నియంత్రించవచ్చు . మీ శరీర రోగనిరోధక శక్తిని బలోపేతం చేయవచ్చు.
తెల్ల రక్త కణాలు ఎక్కువగా ఉన్నప్పుడు ఏమి తినాలి?

తెల్ల రక్త కణాలు ఎక్కువగా ఉన్నప్పుడు వాటి సంఖ్యను నియంత్రించడానికి, శరీరంలోని రుగ్మత, లేదా పరిస్థితిని చక్కదిద్దడానికి సమతుల్య పోషకాహారం చాలా అవసరం. దీంతో పాటు శరీరంలోని రోగనిరోధక శక్తికి బూస్ట్ ఇచ్చేందుకు ఇమ్యూనిటీతో కూడిన ఆహారం కూడా చాలా ముఖ్యం. తెల్ల రక్త కణాలు కౌంట్ ఎక్కువగా ఉంటే తీసుకునే ఆహారం గురించి జాగ్రత్త వహించడం చాలా ముఖ్యం. సరైన ఆహారాన్ని తీసుకోవడం ద్వారా, మీరు వేగవంతమైన మెరుగుదలను అనుభవించవచ్చు.
- బొప్పాయి మరియు స్ట్రాబెర్రీ వంటి కాలానుగుణ పండ్లు.
- పాలకూర మరియు మెంతులు వంటి ఆకుకూరలు.
- తేలికపాటి ప్రోటీన్ వనరులు: కాయధాన్యాలు, చిక్పీస్, ముంగ్ బీన్స్.
- ఒమేగా-3 అధికంగా ఉండే ఆహారాలు: అవిసె గింజలు, వాల్నట్స్.
- తగినంత నీరు మరియు హైడ్రేటింగ్ ద్రవాలు.
- జీర్ణమయ్యే ఆహారాలు: కిచ్డి, గంజి.
మీ తెల్ల రక్త కణాలు కౌంట్ పెరిగినప్పుడు ఏమి తినకూడదు?
కొన్ని ఆహారాలు మీ రోగనిరోధక శక్తిని ప్రతికూలంగా ప్రభావితం చేస్తాయి మరియు తెల్ల రక్త కణాలు కౌంట్ అసమతుల్యతకు దారితీస్తాయి. ఈ ఆహారాలను నివారించడం వల్ల మీ శరీరం ఆరోగ్యంగా మరియు సమతుల్యంగా ఉంటుంది.
వీటిని నివారించండి:
- ఫాస్ట్ ఫుడ్ మరియు జంక్ ఫుడ్.
- ఎర్ర మాంసం మరియు అధిక కొవ్వు మాంసాలు.
- వేయించిన మరియు భారీ ఆహారాలు.
- ప్రాసెస్ చేయబడిన మరియు ప్యాక్ చేయబడిన స్నాక్స్.
- శీతల పానీయాలు మరియు తీపి పానీయాలు.
- అధిక ఉప్పు మరియు చక్కెర కలిగిన పదార్థాలు.
చివరిగా.!
తెల్ల రక్త కణాలు (WBC) స్థాయిలు మీ శరీర రోగనిరోధక వ్యవస్థ మరియు ఆరోగ్య స్థితిని సూచిస్తాయి. తెల్ల రక్త కణాలులు పెరిగినప్పుడు, అది తరచుగా ఇన్ఫెక్షన్, వాపు, అలెర్జీ లేదా తీవ్రమైన అనారోగ్యానికి సంకేతం కావచ్చు. పెరిగిన తెల్ల రక్త కణాల గణన ప్రతిసారి తీవ్రమైన సమస్య కాకపోయినా, దానిని విస్మరించడం ప్రమాదకరం కావచ్చు. సరైన పరీక్షలు మరియు సకాలంలో వైద్య సలహా తెల్ల రక్త కణాలులను అదుపులో ఉంచడానికి మరియు ఏవైనా అంతర్లీన అనారోగ్యాలను ముందుగానే గుర్తించడంలో సహాయపడుతుంది.
సమతుల్య మరియు పోషకమైన ఆహారం, తగినంత నీరు తీసుకోవడం, క్రమం తప్పకుండా వ్యాయామం, మంచి నిద్ర మరియు ఒత్తిడి తగ్గింపు సాధారణ తెల్ల రక్త కణాలు గణనలను నిర్వహించడానికి సహాయపడతాయి. జంక్ ఫుడ్, వేయించిన ఆహారాలు, మద్యం మరియు ధూమపానం మానుకోవడం కూడా ముఖ్యం. తరచుగా అలసట, జ్వరం, బలహీనత లేదా ఇన్ఫెక్షన్లు వంటి శరీర సంకేతాలకు శ్రద్ధ వహించండి. మీ శరీర రక్షణ మరియు దీర్ఘకాలిక ఆరోగ్యానికి తెల్ల రక్త కణాలు సమతుల్యత చాలా ముఖ్యమైనది. ఆరోగ్యకరమైన జీవనశైలిని అవలంబించడం ద్వారా, మీరు బలమైన రోగనిరోధక వ్యవస్థను నిర్వహించవచ్చు మరియు ఆరోగ్యకరమైన జీవితాన్ని గడపవచ్చు.